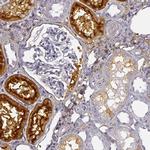
DPEP1 Antibody in Immunohistochemistry (IHC)

Search
Invitrogen
DPEP1 Polyclonal Antibody
{{$productOrderCtrl.translations['antibody.pdp.commerceCard.promotion.promotions']}}
{{$productOrderCtrl.translations['antibody.pdp.commerceCard.promotion.viewpromo']}}
{{$productOrderCtrl.translations['antibody.pdp.commerceCard.promotion.promocode']}}: {{promo.promoCode}} {{promo.promoTitle}} {{promo.promoDescription}}. {{$productOrderCtrl.translations['antibody.pdp.commerceCard.promotion.learnmore']}}
产品信息
PA5-52670
种属反应
宿主/亚型
分类
类型
抗原
偶联物
形式
浓度
规格
纯化类型
保存液
内含物
保存条件
运输条件
RRID
产品详细信息
Immunogen sequence: VMVNFYNNYI SCTNKANLSQ VADHLDHIKE VAGARAVGFG GDFDGVPRVP EGLEDVSKYP DLIAELLRRN WTEAEVKGAL ADNLLRVFQA VEQASNLTQA PEEEPIPLDQ LGGSCRTHYG YSSGAS
Highest antigen sequence identity to the following orthologs: Mouse - 71%, Rat - 72%.
靶标信息
The protein encoded by this gene is a kidney membrane enzyme involved in the metabolism of glutathione and other similar proteins by dipeptide hydrolysis. The encoded protein is known to regulate leukotriene activity by catalyzing the conversion of leukotriene D4 to leukotriene E4. This protein uses zinc as a cofactor and acts as a disulfide-linked homodimer. Two transcript variants encoding the same protein have been found for this gene.
仅用于科研。不用于诊断过程。未经明确授权不得转售。
篇参考文献 (0)
生物信息学
蛋白别名: Beta-lactamase; Dehydropeptidase-I; Dipeptidase 1; dipeptidase 1 (renal); DPEP1; hRDP; Microsomal dipeptidase; Renal dipeptidase; testicular tissue protein Li 57
基因别名: DPEP1; MBD1; MDP; RDP
UniProt ID: (Human) P16444
Entrez Gene ID: (Human) 1800